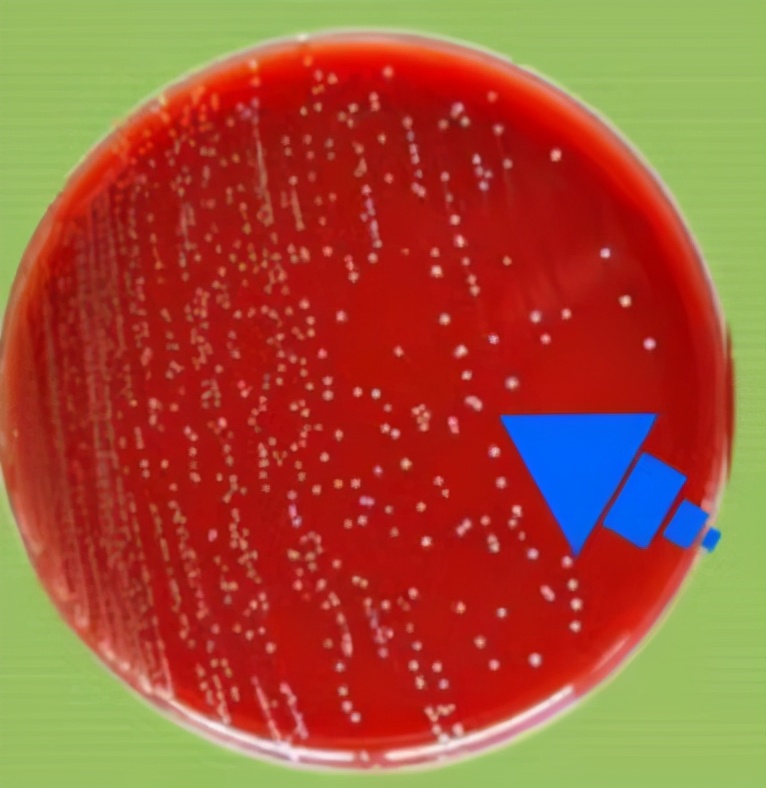
快要做妈妈的你,无乳链球菌筛查做了吗?

稿源:掌上长沙
28岁的李女士结婚5年后终于怀孕,开心又忐忑的她整个孕期小心翼翼,生怕有半点闪失。近日,孕37周的她来到长沙市第三医院例行产检。产科医生告诉她,胎儿发育正常,并给她开具了产前无乳链球菌筛查。
三天后,李女士接到产科的电话,告诉她无乳链球菌筛查结果呈阳性,建议她生产前进行预防性应用抗生素治疗。
李女士很紧张:“无乳链球菌是什么?对我的宝宝有什么影响吗?”
长沙市第三医院医学检验科主任胡方兴介绍,无乳链球菌又叫B群链球菌,简称GBS ,正常寄居于阴道和直肠。
显微镜下的无乳链球菌。医院 供图
GBS是一种条件致病菌,正常健康人群感染后一般并不会致病。孕期妇女因为体内激素水平变化使生殖道内环境发生改变,而容易感染无乳链球菌。由于孕妇的抵抗力下降, GBS顺着阴道感染孕妇的宫颈、子宫内膜,感染后可表现为菌血症、泌尿系统感染、胎膜感染、子宫内膜感染以及创伤感染。
经过预防性应用抗生素后,李女士在长沙市第三医院顺利地产下一名健康女婴,孩子出生后经筛查并未感染无乳链球菌,李女士悬着的心终于放了下来。
根据美国疾病控制与预防中心统计,约有10%至30%的孕妇感染有无乳链球菌,其中40%至70%的孕妇在分娩过程中会将无乳链球菌经过产道传染给新生儿。
根据研究,如果新生儿携带了这种细菌,约有1%至3%的概率会出现早期侵入性感染,导致败血症、肺炎和脑膜炎,造成孩子出现耳聋、视力受损、发育障碍以及脑瘫等可能,甚至有一定死亡率。
“基于无乳链球菌感染引起孕妇和新生儿相关症状疾病的严重性,产前筛查无乳链球菌尤为重要。”胡方兴表示,怀孕35周至37周的孕妇均须进行阴道和直肠的无乳链球菌筛查。
即使感染了无乳链球菌,孕妈妈们不必过于担心,通过抗生素预防能够有效降低无乳链球菌垂直传播引起新生儿早期宫内感染。
胡方兴介绍,最常用的治疗方法就是分娩前(至少前4小时)根据实验室的药敏结果选择抗生素进行抗生素预防,或者经验性使用青霉素输注。只要提前使用抗生素,宝宝感染的风险就会大大降低。
相关链接:
1.哪类人群需要进行无乳链球菌筛查?
①GBS带菌的高危孕妇于产前或产时重复检查;
②孕期没有做过GBS筛查的孕妇在生产时和生产后;
③胎膜早破;
④早产;
⑤产时发热超过38℃;
⑥GBS阳性孕妇新生儿出生后;
⑦产程发生宫内感染的孕妇及新生儿。
2. 无乳链球菌是如何筛查的?
无乳链球菌的筛查很简单,仅需要采集孕妇阴道下1/3位置和肛门样本;新生儿则取其鼻腔和咽部的分泌物,进行48小时的细菌培养即可。
3. 孕妇感染无乳链球菌还可以顺产吗?
感染无乳链球菌的孕妇无论是顺产还是剖腹产,新生儿都会有感染的风险,而经过抗生素预防可以大大降低新生儿感染的风险。因此,无乳链球菌阳性孕妇是可以顺产的,不建议单纯因为无乳链球菌阳性而选择剖腹产。